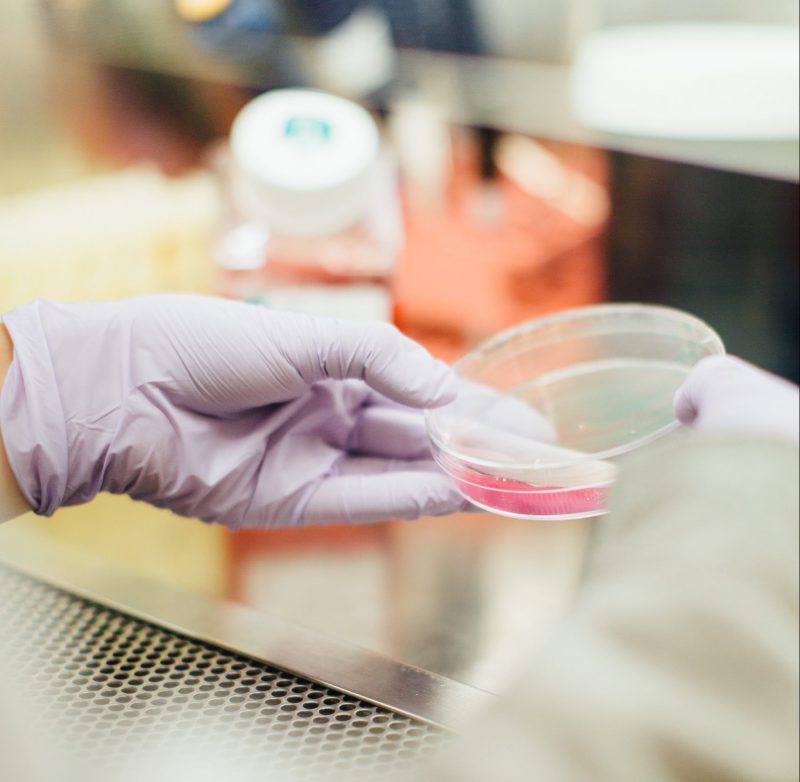
Fungo Penicillium Chrysogenum provocou a morte de uma adolescente de 14 anos no Rio de Janeiro – Foto: Divulga&ccedil;&atilde;o/Unsplash/ND

O primeiro caso de meningoencefalite causada pelo fungo Penicillium Chrysogenum provocou a morte de uma adolescente de 14 anos no Rio de Janeiro, segundo a Fiocruz.
Fungo Penicillium Chrysogenum provocou a morte de uma adolescente de 14 anos no Rio de Janeiro – Foto: Divulgação/Unsplash/ND
Fungo Penicillium Chrysogenum provocou a morte de uma adolescente de 14 anos no Rio de Janeiro – Foto: Divulgação/Unsplash/NDO microrganismo é raramente identificado como agente etiológico de doenças em humanos, mas provocou uma infecção grave no cérebro e meninges à jovem. O relato foi publicado no periódico científico International Journal of Infectious Diseases.
O caso foi acompanhado no Hospital Naval Marcílio Dias, na Zona Norte. A adolescente foi admitida no centro médico com dores de cabeça, fotofobia (intolerância à luz) e vômito.
SeguirA Dive/SC (Diretoria de Vigilância Epidemiológica de Santa Catarina) informou que não há casos no Estado e reforçou que a infecção é bastante rara.
Evolução da doença
Conforme os exames, a jovem não apresentava comorbidades e aparentava possuir capacidade de reagir contra a infecção. A presença do fungo foi observada em análises do líquido cefalorraquidiano — substância que envolve o cérebro e a medula espinhal.
As amostras foram enviadas para identificação mais detalhada no Laboratório de Taxonomia, Bioquímica e Bioprospecção de Fungos do Instituto Oswaldo Cruz.
“Os quadros de meningoencefalite são comumente associados a infecções provocadas por bactérias ou por fungos do gênero Cryptococcus. Foi um espanto identificar que este caso estava relacionado ao Penicillium, e de uma espécie que ainda não tinha sido descrita no país como causadora dessa doença”, destaca o pesquisador do Laboratório do Instituto Oswaldo Cruz e coordenador do artigo, Manoel Marques Evangelista de Oliveira.
Tratamento
Com a confirmação, os médicos do Marcílio Dias iniciaram tratamento da jovem com duas classes de medicamentos antifúngicos. Apesar dos esforços, a paciente morreu em decorrência de choque séptico e neurogênico.
“A gravidade desse caso nos preocupa por ter ocorrido principalmente em uma paciente imunocompetente, pois pode significar que o P. chrysogenum tem um perfil de escape da resposta imunológica. O caso poderia ter tido uma evolução ainda mais rápida e complicada em pacientes com a imunidade comprometida, como pessoas com HIV/Aids ou em tratamento da Covid-19”, explica Manoel.
Ampliar estudos
Para o pesquisador, o achado demonstra a necessidade de uma identificação rápida e precisa de agentes etiológicos e a importância de ampliar os estudos acerca de fungos patogênicos.
“O nosso artigo serve de alerta para médicos considerarem mais constantemente os fungos em seus diagnósticos, como foi feito pelo Hospital Naval Marcílio Dias. Assim como vírus e bactérias, os fungos podem provocar diversas doenças. Porém, como não são muito lembrados, vários casos são tratados tardiamente ou passam despercebidos”, conclui Manoel.
A forma como a paciente foi infectada pelo P. chrysogenum não ficou evidente. Embora o fungo esteja amplamente distribuído no ambiente, é mais comum encontrá-lo em solos onde há matéria em decomposição, passagem de esgotos e obras.
*Com informações da Fiocruz




